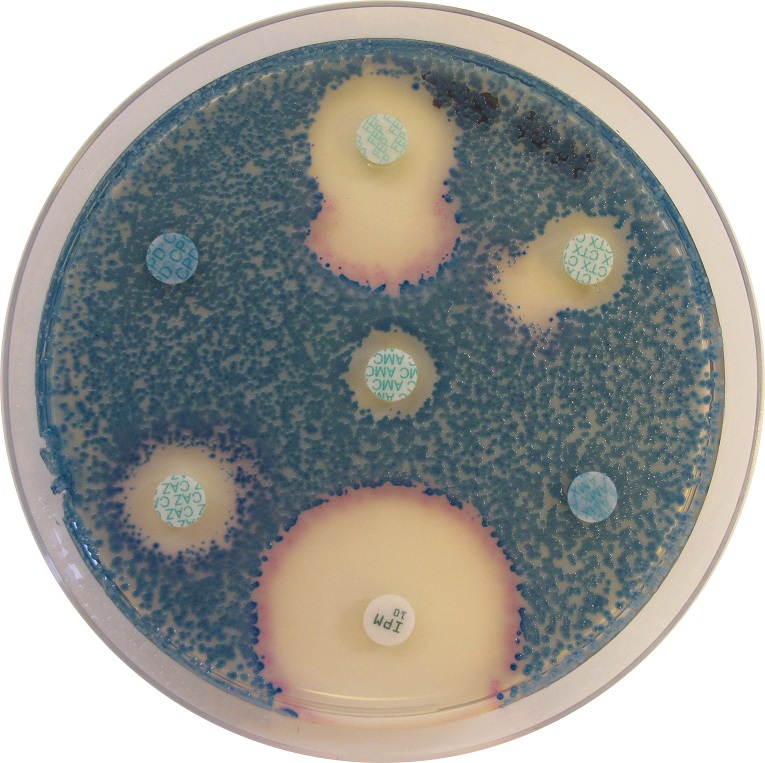

- Esileht
-
Pädevusvaldkond
- Ettevõttest
- Kontaktandmed
- Esileht
- Pädevusvaldkond
- Mikrobioloogilised külvid
- Söötmed ja suplemendid
CHROMagar™ MH Orientation
Tootekood: MH483-25
Tootja: CHROMagar
Pakend: 25000 ml
NB! Saate tellida tooteid veebipoes. Logige sisse lehe paremas ülanurgas.
Product information
CHROMagar™ MH Orientation on kromogeenne Müller Hinton agar, milles on ühendatud kromogeensöötme eelised ja antibiootikumide tundlikkuse määramine. CHROMagar™ MH Orientation annab vastused otse esmakülvilt enamikele mikroobidele/antibiootikumidele juba peale 18 tunnist inkubeerimist, samas traditsiooniliselt kasutatud meeetodid võivad võtta aega 48 tundi.
Võtke ühendust meie spetsialistiga
Küsige lisa infot Labema spetsialistilt. Toote spetsialist on Markus Pappa.